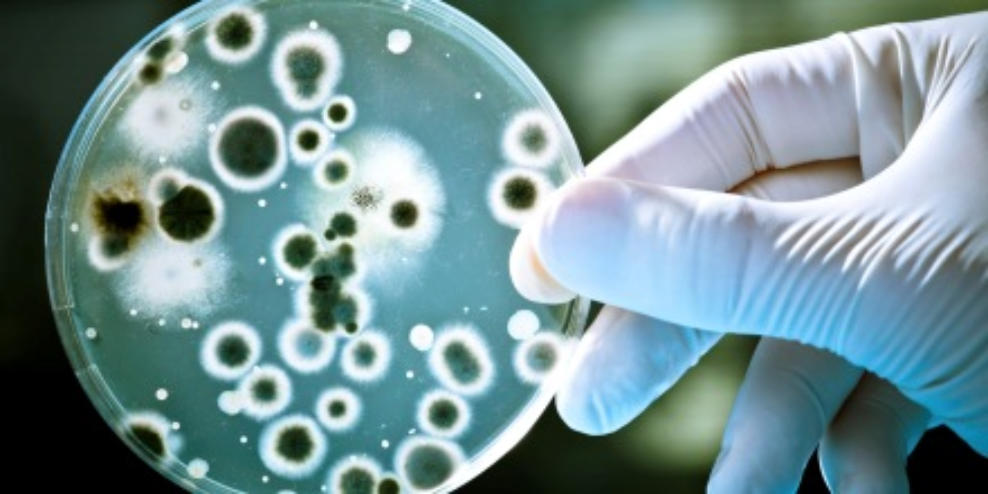

Wie die Welt aufgebaut ist....
...Welten in Welten in Welten von Welten..
in Welten......
Selbst die Haut ist dicht besiedelt.
In unserem Körper sind ca. 2 Kilo Bakterien
leben überall...
und lebensräume auch
Gut gegen böse?




Ur- Lebensformen ohne die nichts geht, winzig klein
und gleichzeitig sehr sehr mächtig

